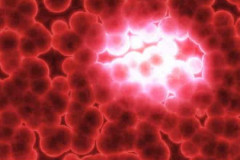

Life
 Ահա թե ինչ դիրքով է անհրաժեշտ քնել, որպեսզի ազատվեք ցավերից, ավելորդ քաշից և ոչ ...
Ահա թե ինչ դիրքով է անհրաժեշտ քնել, որպեսզի ազատվեք ցավերից, ավելորդ քաշից և ոչ ...
 4 բաղադրիչներից բաղկացած հզոր միջոց ընդդեմ դիաբետի, արթրիտի, մրսածության և այլ խ...
4 բաղադրիչներից բաղկացած հզոր միջոց ընդդեմ դիաբետի, արթրիտի, մրսածության և այլ խ...
 Համեղ նախաճաշ, որը կմաքրի ձեր օրգանիզմը տոքսիներից և կօգնի ամսեկան ազատվել 5 կգ ...
Համեղ նախաճաշ, որը կմաքրի ձեր օրգանիզմը տոքսիներից և կօգնի ամսեկան ազատվել 5 կգ ...
 Այս բաղադրատոմսով պատրաստված թեյը օգնում է բուժել անքնությունը․ Հրաշք միջոց
Այս բաղադրատոմսով պատրաստված թեյը օգնում է բուժել անքնությունը․ Հրաշք միջոց
 Արքայախնձորը և ալոե վերան պատրաստելու ճիշտ տարբերակ, որը կօգնի ազատվել ավելորդ ք...
Արքայախնձորը և ալոե վերան պատրաստելու ճիշտ տարբերակ, որը կօգնի ազատվել ավելորդ ք...
 Փորձեք այս մազերի դիմակը մեկ անգամ և դուք այլևս չեք կարողանա դրանից հրաժարվել
Փորձեք այս մազերի դիմակը մեկ անգամ և դուք այլևս չեք կարողանա դրանից հրաժարվել
 Այս սուպեր բնական միջոցը բուժում է դիաբետը և վերացնում ուռուցքները
Այս սուպեր բնական միջոցը բուժում է դիաբետը և վերացնում ուռուցքները
 Մեղրադարչնային ըմպելիք․ Այն օգնում է արագ ազատվել ավելորդ քաշից, անգամ ամենագեր ...
Մեղրադարչնային ըմպելիք․ Այն օգնում է արագ ազատվել ավելորդ քաշից, անգամ ամենագեր ...
 Իմանալով այս մասին, դուք այլևս դեն չեք նետի կարտոֆիլի կեղևները․ ահա թե ինչու
Իմանալով այս մասին, դուք այլևս դեն չեք նետի կարտոֆիլի կեղևները․ ահա թե ինչու
 Այս ըմպելիքը կօգնի մաքրել լյարդը և վերացնել օրգանիզմում կուտակված տոքսիները
Այս ըմպելիքը կօգնի մաքրել լյարդը և վերացնել օրգանիզմում կուտակված տոքսիները
 Ռուսական բաղադրատոմս, որը շատ արագ պայքարում է վարիկոզի դեմ
Ռուսական բաղադրատոմս, որը շատ արագ պայքարում է վարիկոզի դեմ
 Սուպերհզոր դիմակ, որը արագացնում է մազերի աճը, դարձնելով մազերը ամուր և խիտ
Սուպերհզոր դիմակ, որը արագացնում է մազերի աճը, դարձնելով մազերը ամուր և խիտ
 Ազատվեք ձեր մարմնի տոքսիներից շնորհիվ այս հրաշք ըմպելիքի․ Այն ուղղակի անհավանակա...
Ազատվեք ձեր մարմնի տոքսիներից շնորհիվ այս հրաշք ըմպելիքի․ Այն ուղղակի անհավանակա...
 Վերականգնեք մաշկը, մազերը և վերացրեք հոդերի ցավը շնորհիվ այս հրաշք միջոցի
Վերականգնեք մաշկը, մազերը և վերացրեք հոդերի ցավը շնորհիվ այս հրաշք միջոցի
 Համեղ թեյ, որն ազատում է այտուցներից, ավելորդ քաշից և պաշտպանում սիրտը հիվանդութ...
Համեղ թեյ, որն ազատում է այտուցներից, ավելորդ քաշից և պաշտպանում սիրտը հիվանդութ...
 Ինչպե՞ս բուժել սիրտը խոտաբույսերի միջոցով
Ինչպե՞ս բուժել սիրտը խոտաբույսերի միջոցով
 Եռացրեք բանանն ու դարչինը և խմեք այն քնելուց մեկ ժամ առաջ․ Ահա, թե ինչ կկատարվի ...
Եռացրեք բանանն ու դարչինը և խմեք այն քնելուց մեկ ժամ առաջ․ Ահա, թե ինչ կկատարվի ...
 Ոտքերի ոսկորների գերաճը միանգամից վերանում է․ Մեր տատիկները իմացել են այս գաղտնի...
Ոտքերի ոսկորների գերաճը միանգամից վերանում է․ Մեր տատիկները իմացել են այս գաղտնի...
 Այս հին գերմանական միջոցը մաքրում է զարկերակները, ամրացնում իմունային համակարգը ...
Այս հին գերմանական միջոցը մաքրում է զարկերակները, ամրացնում իմունային համակարգը ...
 Ուզու՞մ եք ունենալ բարակ որովայն․ Շնորհիվ այս ըմպելիքի դուք կարող եք հեշտությամբ...
Ուզու՞մ եք ունենալ բարակ որովայն․ Շնորհիվ այս ըմպելիքի դուք կարող եք հեշտությամբ...
 Այս նյութը կարդալուց հետո կհրաժարվեք պլաստմասե շշերի օգտագործումից
Այս նյութը կարդալուց հետո կհրաժարվեք պլաստմասե շշերի օգտագործումից
 Կիտրոնի հյութը և սննդի սոդան կարող են փրկել ձեր կյանքը․ ահա, թե ինչպես
Կիտրոնի հյութը և սննդի սոդան կարող են փրկել ձեր կյանքը․ ահա, թե ինչպես
 Խմեք այս խառնուրդը քնելուց առաջ և դուք կմաքրեք ձեր օրգանիզմից այն ամենը, ինչ կեր...
Խմեք այս խառնուրդը քնելուց առաջ և դուք կմաքրեք ձեր օրգանիզմից այն ամենը, ինչ կեր...
 Հարևանս կիսվեց ինձ հետ մի շատ արդյունավետ միջոցով․ Նա օգտագործում է այս միջոցը և...
Հարևանս կիսվեց ինձ հետ մի շատ արդյունավետ միջոցով․ Նա օգտագործում է այս միջոցը և...
 Այս միջոցը կօգնի ձեզ բարելավվել տեսողությունը և ունենալ 15 տարով ավելի երիտասարդ...
Այս միջոցը կօգնի ձեզ բարելավվել տեսողությունը և ունենալ 15 տարով ավելի երիտասարդ...
 Այս շատ հզոր միջոցը կօգնի ձեզ ազատվել եղունգների անգամ ամենաբարդ սնկերից
Այս շատ հզոր միջոցը կօգնի ձեզ ազատվել եղունգների անգամ ամենաբարդ սնկերից
 Ահա թե ինչ են խորհուրդ տալիս ուտել մասնագետները , որպեսզի ազատվեք մազաթափություն...
Ահա թե ինչ են խորհուրդ տալիս ուտել մասնագետները , որպեսզի ազատվեք մազաթափություն...
 Ինչու՞ ես այս մասին ավելի շուտ չգիտեի․ ահա թե ինչու ես երկար ժամանակ չէի կարողան...
Ինչու՞ ես այս մասին ավելի շուտ չգիտեի․ ահա թե ինչու ես երկար ժամանակ չէի կարողան...
 Նա 60 տարեկան է և այս աղցանը օգնել է նրան վերականգնել տեսողությունը, մաքրել լյար...
Նա 60 տարեկան է և այս աղցանը օգնել է նրան վերականգնել տեսողությունը, մաքրել լյար...
 Ընդամենը 2 րոպե և ձեր կրունկները կլինեն իդեալական վիճակում, առանց որևէ ճաքի կամ ...
Ընդամենը 2 րոպե և ձեր կրունկները կլինեն իդեալական վիճակում, առանց որևէ ճաքի կամ ...
 Կոտայքի մարզի մի շարք բնակավայրերում 8 ժամ ջուր չի լինի
Կոտայքի մարզի մի շարք բնակավայրերում 8 ժամ ջուր չի լինի Աղքատությունը աճում է Վայոց Ձորում․ Նարեկ Կարապետյան
Աղքատությունը աճում է Վայոց Ձորում․ Նարեկ Կարապետյան Քարոզարշավ օր 3-րդ. ՈՒժեղ Եղեգնաձոր․ Նարեկ Կարապետյան
Քարոզարշավ օր 3-րդ. ՈՒժեղ Եղեգնաձոր․ Նարեկ Կարապետյան Նարեկ Կարապետյանը Եղեգնաձորից տեսանյութ է հրապարակել
Նարեկ Կարապետյանը Եղեգնաձորից տեսանյութ է հրապարակել ԲՀԿ նախընտրական ցուցակի անդամ Սուրեն Սուրենյանցը պատասխանում է քաղաքական օրակարգին և հանրությանը հետաքրքրող կարևոր հարցերին
ԲՀԿ նախընտրական ցուցակի անդամ Սուրեն Սուրենյանցը պատասխանում է քաղաքական օրակարգին և հանրությանը հետաքրքրող կարևոր հարցերին Աբովյանում կրկին ընդգծվեց գլխավոր ուղերձը՝ խաղաղ ու բարեկեցիկ Հայաստան յուրաքանչյուր ընտանիքի համար․ Գագիկ Ծառուկյան
Աբովյանում կրկին ընդգծվեց գլխավոր ուղերձը՝ խաղաղ ու բարեկեցիկ Հայաստան յուրաքանչյուր ընտանիքի համար․ Գագիկ Ծառուկյան 8 տարի անց Հայաստանում անկախ դատական իշխանություն չկա․ Էդմոն Մարուքյան
8 տարի անց Հայաստանում անկախ դատական իշխանություն չկա․ Էդմոն Մարուքյան Նարեկ Կարապետյանի ելույթը Վայքում
Նարեկ Կարապետյանի ելույթը Վայքում «Ուժեղ Հայաստան»- ի ուղիղ եթերը Վայքից
«Ուժեղ Հայաստան»- ի ուղիղ եթերը Վայքից Վայքն էլ է սպասում փոփոխության․ միասին ենք Հայաստանը ուժեղ դարձնելու
Վայքն էլ է սպասում փոփոխության․ միասին ենք Հայաստանը ուժեղ դարձնելու Փաշինյանը վարչապետն է, նախագահը, ԱԱԾ պետը, գլխավոր դատավորը, ԲԴԽ Նախագահը ու այդպես շարունակ․ Էդմոն Մարուքյան
Փաշինյանը վարչապետն է, նախագահը, ԱԱԾ պետը, գլխավոր դատավորը, ԲԴԽ Նախագահը ու այդպես շարունակ․ Էդմոն Մարուքյան «Ուժեղ Հայաստանի» քարոզարշավը Եղեգնաձորում
«Ուժեղ Հայաստանի» քարոզարշավը Եղեգնաձորում «Ուժեղ Հայաստան» քարոզարշավը․ ուղիղ
«Ուժեղ Հայաստան» քարոզարշավը․ ուղիղ Զգուշացում․ Հայաստանում վտանգավոր թեյնիկներ են հայտնաբերվել
Զգուշացում․ Հայաստանում վտանգավոր թեյնիկներ են հայտնաբերվել «ԲԱՐԳԱՎԱՃ ՀԱՅԱՍՏԱՆ» կուսակցության նախընտրական ծրագրի հիմնադրույթները
«ԲԱՐԳԱՎԱՃ ՀԱՅԱՍՏԱՆ» կուսակցության նախընտրական ծրագրի հիմնադրույթները Ինձ առավելագույն պայմաններն էին առաջարկում՝ մի հայտարարության դիմաց, որ քաղաքականություն չեմ մտնելու․ Կարապետյան
Ինձ առավելագույն պայմաններն էին առաջարկում՝ մի հայտարարության դիմաց, որ քաղաքականություն չեմ մտնելու․ Կարապետյան Հրաժարում «վարկային ստրկությունից». Սամվել Կարապետյանն առաջարկել է երաշխավորված եկամուտների համակարգ
Հրաժարում «վարկային ստրկությունից». Սամվել Կարապետյանն առաջարկել է երաշխավորված եկամուտների համակարգ Սյունիքն ու Մեղրին դատապարտված են լավ ապրելու. Նարեկ Կարապետյան
Սյունիքն ու Մեղրին դատապարտված են լավ ապրելու. Նարեկ Կարապետյան Փոփոխություններ՝ պարտադիր զինծառայության անցնողների համար․ նախագիծ
Փոփոխություններ՝ պարտադիր զինծառայության անցնողների համար․ նախագիծ Իրազեկում․ Արագածոտնի մարզի Պարտիզակ բնակավայրում փորձարկվելու է էլեկտրական շչակ
Իրազեկում․ Արագածոտնի մարզի Պարտիզակ բնակավայրում փորձարկվելու է էլեկտրական շչակ Հունիս ամսվա ոչ աշխատանքային և տոնական օրերը
Հունիս ամսվա ոչ աշխատանքային և տոնական օրերը Ուղիղ․ «Հայաստան» դաշինքի անդամները՝ Ռոբերտ Քոչարյանի գլխավորությամբ Իջևանում են
Ուղիղ․ «Հայաստան» դաշինքի անդամները՝ Ռոբերտ Քոչարյանի գլխավորությամբ Իջևանում են Բժիշկը պարզաբանել է՝ ինչպես է նստակյաց ապրելակերպը վնասում սրտին
Բժիշկը պարզաբանել է՝ ինչպես է նստակյաց ապրելակերպը վնասում սրտին Մարդիկ իրենց գումարները ծախսելու են բարեկեցության, ոչ թե նարկոտիկներ օգտագործելու կամ խաղամոլությամբ զբաղվելու վրա. Կարապետյան (Տեսանյութ)
Մարդիկ իրենց գումարները ծախսելու են բարեկեցության, ոչ թե նարկոտիկներ օգտագործելու կամ խաղամոլությամբ զբաղվելու վրա. Կարապետյան (Տեսանյութ) Սրանց համար մեկ սկզբունք կա. ոնց անեն 300 հազար ադրբեջանցի բերեն, տեղավորեն. Սամվել Կարապետյան
Սրանց համար մեկ սկզբունք կա. ոնց անեն 300 հազար ադրբեջանցի բերեն, տեղավորեն. Սամվել Կարապետյան Պարտվել չի նշանակում լինել սխալ. Ալիևի հայտարարության մասին․ Էդմոն Մարուքյան
Պարտվել չի նշանակում լինել սխալ. Ալիևի հայտարարության մասին․ Էդմոն Մարուքյան 6,9 մլրդ ամն դոլարի սուտը․ Հրայր Կամենդատյան
6,9 մլրդ ամն դոլարի սուտը․ Հրայր Կամենդատյան Ուղիղ. «Հայաստան» դաշինքի անդամները Դիլիջանում են
Ուղիղ. «Հայաստան» դաշինքի անդամները Դիլիջանում են Հաջորդ վարչապետ Սամվել Կարապետյանը լսում է գյուղերի խնդիրներն ու առաջարկում լուծումներ
Հաջորդ վարչապետ Սամվել Կարապետյանը լսում է գյուղերի խնդիրներն ու առաջարկում լուծումներ Բախվել են Վանաձոր–Սպիտակ–Լեռնավան երթուղին սպասարկող «Գազել»-ը ու «ՈւԱԶ»-ը․ կա 6 վիրավnր
Բախվել են Վանաձոր–Սպիտակ–Լեռնավան երթուղին սպասարկող «Գազել»-ը ու «ՈւԱԶ»-ը․ կա 6 վիրավnր
 Գագիկ Ծառուկյանը բացառել է Նիկոլ Փաշինյանի հետ կոալիցիա կազմելու հնարավորությունը
Գագիկ Ծառուկյանը բացառել է Նիկոլ Փաշինյանի հետ կոալիցիա կազմելու հնարավորությունը «Համահայկական ճակատ» կուսակցության ներկայացուցիչ, ԶՈւ պահեստազորի գնդապետ Արտյոմ Սիմոնյանի գրառումը
«Համահայկական ճակատ» կուսակցության ներկայացուցիչ, ԶՈւ պահեստազորի գնդապետ Արտյոմ Սիմոնյանի գրառումը Փոփոխությունը բերել ենք Ագարակ. Փոփոխություն հնարավոր է միայն հաջորդ վարչապետ Սամվել Կարապետյանի հետ. Նարեկ Կարապետյան
Փոփոխությունը բերել ենք Ագարակ. Փոփոխություն հնարավոր է միայն հաջորդ վարչապետ Սամվել Կարապետյանի հետ. Նարեկ Կարապետյան Մինչև ընտրությունների օրը ընդդիմադիր դաշտում համախմբումը կարող է շարունակվել․ Ավետիք Չալաբյան
Մինչև ընտրությունների օրը ընդդիմադիր դաշտում համախմբումը կարող է շարունակվել․ Ավետիք Չալաբյան Ագարակն ընտրում է փոփոխությունը․ փոփոխություն հնարավոր է միա՛յն հաջորդ վարչապետ Սամվել Կարապետյանի հետ
Ագարակն ընտրում է փոփոխությունը․ փոփոխություն հնարավոր է միա՛յն հաջորդ վարչապետ Սամվել Կարապետյանի հետ Եկեղեցին մեկ այցով խուճապի մատնեց իշխանությանը
Եկեղեցին մեկ այցով խուճապի մատնեց իշխանությանը
 Թուրք լրագրողներն այցելել են Գյումրի՝ հայ-թուրքական սահման
Թուրք լրագրողներն այցելել են Գյումրի՝ հայ-թուրքական սահման
 Փոփոխութան քարոզարշավը Մեղրիում է. փոփոխություն հնարավոր է միա՛յն հաջորդ վարչապետ Սամվել Կարապետյանի հետ
Փոփոխութան քարոզարշավը Մեղրիում է. փոփոխություն հնարավոր է միա՛յն հաջորդ վարչապետ Սամվել Կարապետյանի հետ Գագիկ Ծառուկյանը՝ Հայաստանի ազգային շահի և Էմանուել Մակրոնի մասին
Գագիկ Ծառուկյանը՝ Հայաստանի ազգային շահի և Էմանուել Մակրոնի մասին Կրթական համակարգի կազմաքանդումը լուռ ցեղասպանություն է․ Ատոմ Մխիթարյան
Կրթական համակարգի կազմաքանդումը լուռ ցեղասպանություն է․ Ատոմ Մխիթարյան 57-ամյա Շիոն ընտրվել է Վրաստանի նոր պատրիարք
57-ամյա Շիոն ընտրվել է Վրաստանի նոր պատրիարք
 «Հայաքվեի» աջակցությամբ նկարահանված «Ծիծեռնակի հավատի կենացը» ֆիլմն ընդգրկվել է «ՄԷԿ ԿԱԴՐ» միջազգային ֆիլմերի փառատոնի «Կինո առանց սահմանի» մրցութային անվանակարգի ծրագրում
«Հայաքվեի» աջակցությամբ նկարահանված «Ծիծեռնակի հավատի կենացը» ֆիլմն ընդգրկվել է «ՄԷԿ ԿԱԴՐ» միջազգային ֆիլմերի փառատոնի «Կինո առանց սահմանի» մրցութային անվանակարգի ծրագրում Ժամանակն է, որ Լոնդոնն իր համար սանիտարներ կանչի. Զախարովան՝ Բրիտանիայի նոր պատժամիջnցների մասին
Ժամանակն է, որ Լոնդոնն իր համար սանիտարներ կանչի. Զախարովան՝ Բրիտանիայի նոր պատժամիջnցների մասին
 Ագարակն ընտրում է փոփոխությունը. Ուժեղ Հայաստան
Ագարակն ընտրում է փոփոխությունը. Ուժեղ Հայաստան
 Սպառնալի՞ք, թե՞ զգուշացում Մոսկվայից
Սպառնալի՞ք, թե՞ զգուշացում Մոսկվայից
 Քպ քարոզչություն VS Իրականություն. Նարեկ Կարապետյան
Քպ քարոզչություն VS Իրականություն. Նարեկ Կարապետյան
 Փաշինյանն արդեն անկեղծ է՝ ցույց է տվել իր երկրի հակառակ կողմը. մեծ է ճգնաժամի հավանականությունը. Աննա Կոստանյան
Փաշինյանն արդեն անկեղծ է՝ ցույց է տվել իր երկրի հակառակ կողմը. մեծ է ճգնաժամի հավանականությունը. Աննա Կոստանյան
 Սկսում ենք այն քարոզարշավը, որը կազատագրի հայ ժողովրդին․ Ցոլակ Ակոպյան
Սկսում ենք այն քարոզարշավը, որը կազատագրի հայ ժողովրդին․ Ցոլակ Ակոպյան Կոչ եմ անում բոլորին գնալ ընտրությունների և աջակցել Սամվել Կարապետյանին․ Լիլիա Հարությունյան
Կոչ եմ անում բոլորին գնալ ընտրությունների և աջակցել Սամվել Կարապետյանին․ Լիլիա Հարությունյան Ադրբեջանը բացահայտ աջակցություն է ցուցաբերում Նիկոլ Փաշինյանին
Ադրբեջանը բացահայտ աջակցություն է ցուցաբերում Նիկոլ Փաշինյանին
 1
Ո՞րն է եղել Ռոբերտ Աբաջյանի մոր մահվան պատճառը
1
Ո՞րն է եղել Ռոբերտ Աբաջյանի մոր մահվան պատճառը
 2
Մայրը փորձել է փրկել 7-ամյա տղային, բայց 2-ն էլ խեղդամահ են եղել
2
Մայրը փորձել է փրկել 7-ամյա տղային, բայց 2-ն էլ խեղդամահ են եղել
 3
Երկարատև հիվանդությունից հետո մահացել է Անահիտ Սարգսյանը
3
Երկարատև հիվանդությունից հետո մահացել է Անահիտ Սարգսյանը
 4
Եղբայրները պատվի համար սպանել են իրենց 18-ամյա քրոջը
4
Եղբայրները պատվի համար սպանել են իրենց 18-ամյա քրոջը
 5
Տղամարդը ծեծել է հաշմանդամ տղամարդուն և նրա չորսամյա աուտիզմ ունեցող դստերը
5
Տղամարդը ծեծել է հաշմանդամ տղամարդուն և նրա չորսամյա աուտիզմ ունեցող դստերը
 Փաշինյանը վարչապետն է, նախագահը, ԱԱԾ պետը, գլխավոր դատավորը, ԲԴԽ Նախագահը ու այդպես շարունակ․ Էդմոն Մարուքյան
Փաշինյանը վարչապետն է, նախագահը, ԱԱԾ պետը, գլխավոր դատավորը, ԲԴԽ Նախագահը ու այդպես շարունակ․ Էդմոն Մարուքյան
 Բժիշկը պարզաբանել է՝ ինչպես է նստակյաց ապրելակերպը վնասում սրտին
Բժիշկը պարզաբանել է՝ ինչպես է նստակյաց ապրելակերպը վնասում սրտին
 «Հայաքվեի» աջակցությամբ նկարահանված «Ծիծեռնակի հավատի կենացը» ֆիլմն ընդգրկվել է «ՄԷԿ ԿԱԴՐ» միջազգային ֆիլմերի փառատոնի «Կինո առանց սահմանի» մրցութային անվանակարգի ծրագրում
«Հայաքվեի» աջակցությամբ նկարահանված «Ծիծեռնակի հավատի կենացը» ֆիլմն ընդգրկվել է «ՄԷԿ ԿԱԴՐ» միջազգային ֆիլմերի փառատոնի «Կինո առանց սահմանի» մրցութային անվանակարգի ծրագրում
 Ագարակն ընտրում է փոփոխությունը. Ուժեղ Հայաստան
Ագարակն ընտրում է փոփոխությունը. Ուժեղ Հայաստան
 Հայաստանի իշխանություններից որևէ մեկը քաջություն կունենա՞ ու Ալիևին կհարցնի․ ինչպե՞ս է նա պատկերացնում մեր ժողովուրդը պետք է հարգի իրեն. Մարուքյան
Հայաստանի իշխանություններից որևէ մեկը քաջություն կունենա՞ ու Ալիևին կհարցնի․ ինչպե՞ս է նա պատկերացնում մեր ժողովուրդը պետք է հարգի իրեն. Մարուքյան

 1
1
 2
2
 3
3
 4
4
 5
5
 1
1
2
2
